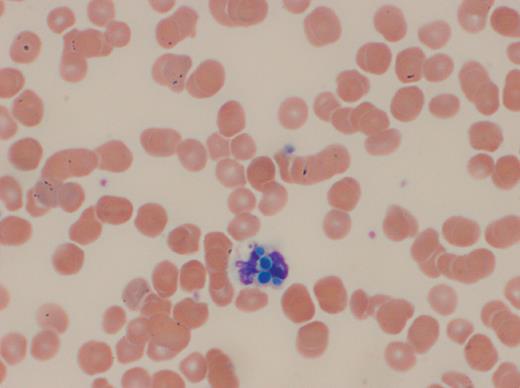
A 17-year-old male with short gut syndrome secondary to Hirschprung disease presented with a 2-week history of night sweats. He had an indwelling central line for total parental nutrition (TPN) supplementation and a history of multiple line infections with a variety of organisms. After completing a 10-day course of prophylactic fluconazole, and 1 week before the onset of night sweats, he had 4 teeth extracted. / Complete blood count showed a leukocyte count of 4.0 × 103/mL (73% neutrophils) and the peripheral blood smear revealed neutrophils with brilliant blue–colored yeast-like intraleukocytic organisms, 2 to 4 μm in diameter (see figure, Wright-Giemsa). The organisms had neither the pseudocapsule or eccentric chromatin suggestive of Histoplasma capsulatum; nor did they produce the “collarettes” indicative of the phialides of Malassezia furfur, a lipid-dependent yeast associated with fungemia in patients requiring TPN. Subsequently, blood cultures grew Candida glabrata. The isolate had a minimum inhibitory concentration of 16 μg/mL to fluconazole and 0.015 μg/mL to micafungin. Anidulafungin therapy was initiated and the infection cleared. / Candida glabrata is a commensal yeast of the gastrointestinal tract and mucocutaneous membranes of humans. It may cause bloodstream infections, especially in immunocompromised individuals or in those with indwelling lines.

A 17-year-old male with short gut syndrome secondary to Hirschprung disease presented with a 2-week history of night sweats. He had an indwelling central line for total parental nutrition (TPN) supplementation and a history of multiple line infections with a variety of organisms. After completing a 10-day course of prophylactic fluconazole, and 1 week before the onset of night sweats, he had 4 teeth extracted.
Complete blood count showed a leukocyte count of 4.0 × 103/mL (73% neutrophils) and the peripheral blood smear revealed neutrophils with brilliant blue–colored yeast-like intraleukocytic organisms, 2 to 4 μm in diameter (see figure, Wright-Giemsa). The organisms had neither the pseudocapsule or eccentric chromatin suggestive of Histoplasma capsulatum; nor did they produce the “collarettes” indicative of the phialides of Malassezia furfur, a lipid-dependent yeast associated with fungemia in patients requiring TPN. Subsequently, blood cultures grew Candida glabrata. The isolate had a minimum inhibitory concentration of 16 μg/mL to fluconazole and 0.015 μg/mL to micafungin. Anidulafungin therapy was initiated and the infection cleared.
Candida glabrata is a commensal yeast of the gastrointestinal tract and mucocutaneous membranes of humans. It may cause bloodstream infections, especially in immunocompromised individuals or in those with indwelling lines.
A 17-year-old male with short gut syndrome secondary to Hirschprung disease presented with a 2-week history of night sweats. He had an indwelling central line for total parental nutrition (TPN) supplementation and a history of multiple line infections with a variety of organisms. After completing a 10-day course of prophylactic fluconazole, and 1 week before the onset of night sweats, he had 4 teeth extracted.
Complete blood count showed a leukocyte count of 4.0 × 103/mL (73% neutrophils) and the peripheral blood smear revealed neutrophils with brilliant blue–colored yeast-like intraleukocytic organisms, 2 to 4 μm in diameter (see figure, Wright-Giemsa). The organisms had neither the pseudocapsule or eccentric chromatin suggestive of Histoplasma capsulatum; nor did they produce the “collarettes” indicative of the phialides of Malassezia furfur, a lipid-dependent yeast associated with fungemia in patients requiring TPN. Subsequently, blood cultures grew Candida glabrata. The isolate had a minimum inhibitory concentration of 16 μg/mL to fluconazole and 0.015 μg/mL to micafungin. Anidulafungin therapy was initiated and the infection cleared.
Candida glabrata is a commensal yeast of the gastrointestinal tract and mucocutaneous membranes of humans. It may cause bloodstream infections, especially in immunocompromised individuals or in those with indwelling lines.
Many Blood Work images are provided by the ASH IMAGE BANK, a reference and teaching tool that is continually updated with new atlas images and images of case studies. For more information or to contribute to the Image Bank, visit http://imagebank.hematology.org.